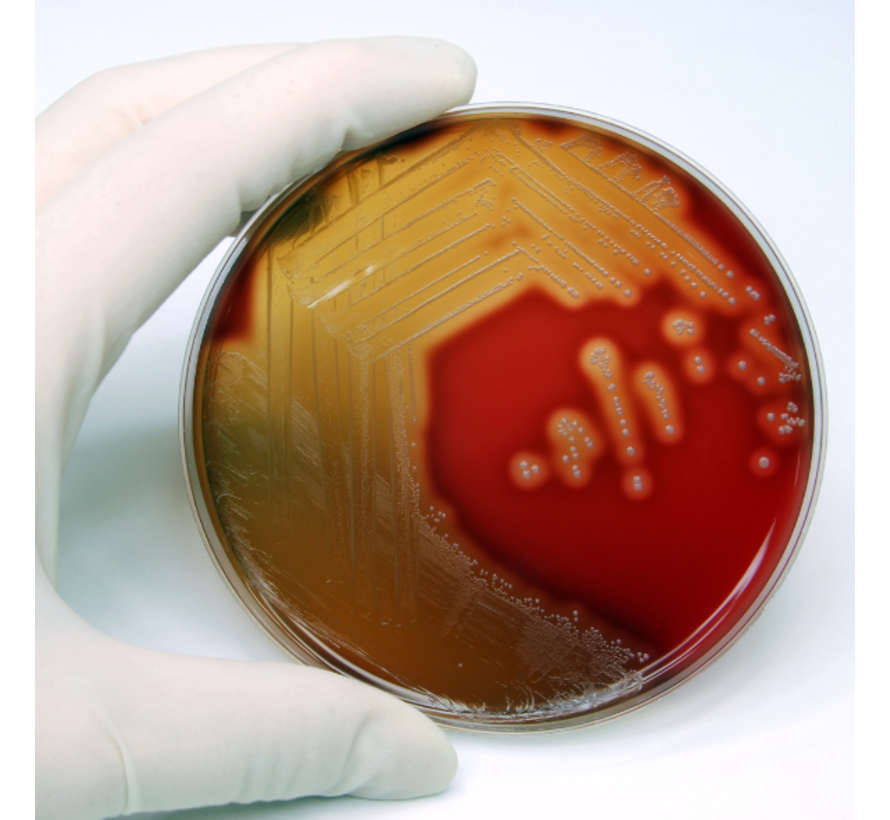

Streptokokken DNAse B-antilichamen (Anti-DNase B)
Streptokokken DNAse B-antilichamen (Anti-DNase B)
Synoniemen:
ADNAse B, anti-streptodornase B, anti-streptokokken DNAse B, anti-DNase B, antistreptodornase B
Categorieën:
Infectiediagnostiek, reactieve artritis, post-streptokokken complicaties
Doel van het onderzoek
Deze test meet antilichamen tegen DNAse B, een enzym dat geproduceerd wordt door groep A streptokokken (Streptococcus pyogenes). Deze antilichamen ontstaan na een doorgemaakte streptokokkeninfectie en kunnen wijzen op complicaties zoals:
• Reumatische koorts
• Post-streptokokken glomerulonefritis
• Huidsuperinfecties
• Reactieve artritis
De Anti-DNase B-test wordt vaak aangevraagd in combinatie met de AST (Antistreptolysine Titer) voor een vollediger beeld van een recente of doorgemaakte streptokokkeninfectie.
Afname en materiaal
• Benodigd monster: 0,50 ml serum
Analyse-informatie
• Methode: NEPH – Nefelometrie
• frequentie analyse 3 keer per week
• Referentiewaarde: < 200 E/ml
• Accreditatie: ISO 15189
Let op:
De Anti-DNase B-test wordt soms verward met de Anti-dsDNA-test, die bedoeld is voor de diagnose van systemische lupus erythematodes (SLE). Deze test is specifiek gericht op streptokokken gerelateerde afweerreacties, en niet op auto-immuunziekten.
EVG16042025